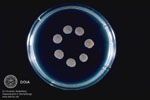
Candida parapsilosis
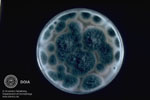
Aspergillus fumigatus
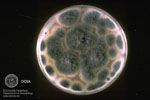
Aspergillus fumigatus

|
Einteilung: Dermatophyten, Hefepilze und Schimmelpilze
Es sind zahlreiche Pilze bekannt, die zu unterschiedlichen Krankheitsbildern führen können. Medizinisch relevante Pilze werden unabhängig von ihrer mikrobiologischen Gattung in das sog. DHS-System eingeteilt.
Dabei wird zwischen Dermatophyten, Hefepilzen und Schimmelpilzen differenziert.
Einige oberflächliche Dermatomykosen wie z.B. Tinea corporis, capitis, barbae, faciei, cruris, pedis oder Candidosen weisen Entzündungszeichen auf, jedoch können einige wie z.B. Pityriasis versicolor auch ohne Entzündungszeichen auftreten. Außerdem wird unterschieden, ob die Mykose an der Haut oberflächlich, unter der Haut (subkutan) oder tief lokalisiert ist.
Dermatophyten
 Tinea corporis
|
Am häufigsten kommen Dermatomykosen vor, die meist durch Dermatophyten hervorgerufen werden. Zur Gruppe der Dermatophyten gehören - Trichophyton (z.B. T. rurbrum, T. mentagrophytes)
- Microsporum (M. canis, M. gypseum)
- Epidermophyton (E. floccosum).
|
 Tinea corporis
|
|
|
 Trichophyton galineae
|
|
|
Hefepilze
Candida parapsilosis
|
Hefepilzinfektionen betreffen häufig die Schleimhaut und können z.B. bei Säuglingen eine Windeldermatitis verursachen. Als Hauptvertreter der Hefepilze gelten- Candida (C. albicans)
- Malassezia furfur (Pityrosporum ovale).
|
Schimmelpilze
Aspergillus fumigatus
|
Schimmelpilze verursachen vergleichsweise zu den oben genannten Pilzen seltener Mykosen. Sie können z.B. eine Onychomykose mit dunklen Verfärbungen bedingen. Die größte Rolle spielen dabei - Aspergillus niger
- Piedraia hortae.
|
Aspergillus fumigatus
|
|
Seltene Pilzarten:
Es existieren zahlreiche, seltene Pilzarten die in den Tropen heimisch sind und zu oberflächlichen Dermatomykosen führen. Bsp.: - Cladosporium wernecki (verursacht Tinea nigra)
- Piedraia hortae (verursacht Piedra nigra)
Außerdem gibt es auch seltene Erreger, die systemischen Mykosen führen wie z.B. - Cryptococcus neoformans (Südeuropa)
- Histoplasmen (Afrika und Amerika)
- Sporothrix schenkii (Tropen/Subtropen)
|